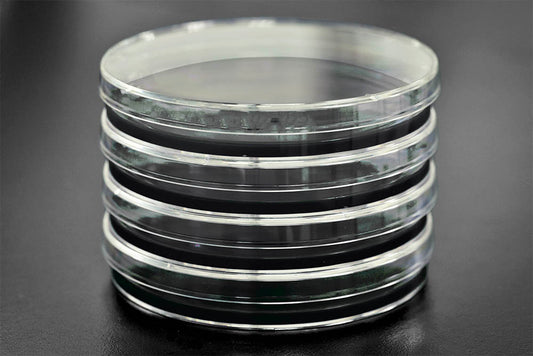
MYA Agar with Carbon – Malt Yeast Agar Plates for Enhanced Growth
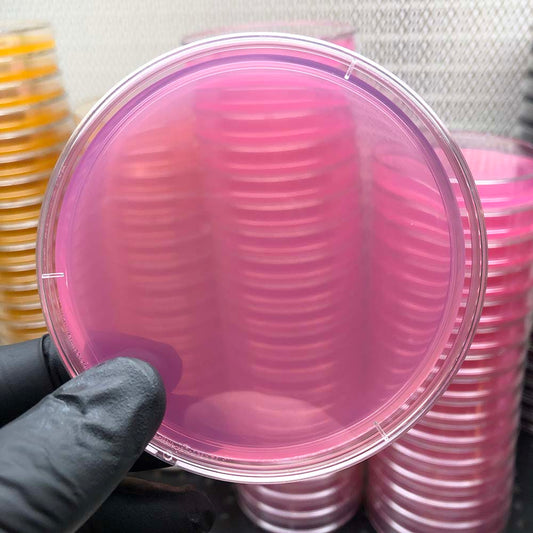
Low Nutrient Agar for Fungi Culturing – Sterile, High-Quality Media
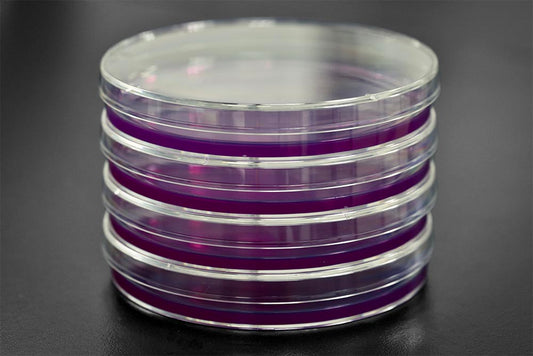
MYA Agar for Fungi Culturing – Sterile, High-Quality Malt Yeast Agar

-
Sustrato de hongos no tan simple
Proveedor:Mycologysimplified4.95 / 5.0
(66) 66 reseñas totales
Precio habitual A partir de $10.00Precio habitualPrecio de oferta A partir de $10.00 -
Pre Poured Sorghum Yeast Agar for Fungi Culturing – Sterile, High-Quality Sorghum Yeast Agar
Proveedor:Mycologysimplified4.92 / 5.0
(53) 53 reseñas totales
Precio habitual A partir de $7.99Precio habitualPrecio de oferta A partir de $7.99 -
Engendro de grano de champiñones de maíz goteante
Proveedor:Mycologysimplified4.91 / 5.0
(53) 53 reseñas totales
Precio habitual $10.00Precio habitualPrecio de oferta $10.00 -
Engendro de grano de champiñón estéril Milo / Sorgo de 3 lb
Proveedor:Mycology Simplified4.96 / 5.0
(26) 26 reseñas totales
Precio habitual $17.99Precio habitualPrecio de oferta $17.99 -
Engendro de grano de champiñón estéril Milo / Sorgo de 3 lb
Proveedor:Mycology Simplified4.87 / 5.0
(52) 52 reseñas totales
Precio habitual $10.00Precio habitualPrecio de oferta $10.00 -
Sustrato simple de hongos
Proveedor:Mycologysimplified4.86 / 5.0
(43) 43 reseñas totales
Precio habitual A partir de $9.00Precio habitualPrecio de oferta A partir de $9.00 -
Engendro de grano de champiñón estéril de mijo de 3 libras
Proveedor:Mycology Simplified4.84 / 5.0
(45) 45 reseñas totales
Precio habitual $10.00Precio habitualPrecio de oferta $10.00Agotado -
Agar MYA con carbono
Proveedor:Mycologysimplified4.85 / 5.0
(39) 39 reseñas totales
Precio habitual A partir de $7.99Precio habitualPrecio de oferta A partir de $7.99 -
Engendro de grano de champiñones de maíz de 3 libras
Proveedor:Mycologysimplified4.73 / 5.0
(15) 15 reseñas totales
Precio habitual $10.00Precio habitualPrecio de oferta $10.00 -
Agar iniciador de esporas bajo en nutrientes
Proveedor:Mycologysimplified5.0 / 5.0
(19) 19 reseñas totales
Precio habitual A partir de $7.99Precio habitualPrecio de oferta A partir de $7.99 -
Peptona de levadura de malta (MYPA)
Proveedor:Mycologysimplified5.0 / 5.0
(10) 10 reseñas totales
Precio habitual A partir de $7.99Precio habitualPrecio de oferta A partir de $7.99 -
Engendro de grano de champiñón estéril Milo / Sorgo de 5 libras
Proveedor:Mycology Simplified4.71 / 5.0
(14) 14 reseñas totales
Precio habitual $15.00Precio habitualPrecio de oferta $15.00 -
Hisopos estériles con punta de algodón
Proveedor:Mycologysimplified5.0 / 5.0
(6) 6 reseñas totales
Precio habitual A partir de $1.00Precio habitualPrecio de oferta A partir de $1.00 -
Cinta MicroPore de 2 pulgadas x 10 yardas
Proveedor:Mycologysimplified5.0 / 5.0
(5) 5 reseñas totales
Precio habitual $3.00Precio habitualPrecio de oferta $3.00 -
Engendro de grano de champiñones de maíz de 5 libras
Proveedor:Mycologysimplified5.0 / 5.0
(11) 11 reseñas totales
Precio habitual $15.00Precio habitualPrecio de oferta $15.00 -
XLS-A HORIZON UnicornBag - Mushroom Grow Bags - 0.5-Micron Gas Exchange Filter Patch
Proveedor:Mycologysimplified5.0 / 5.0
(3) 3 reseñas totales
Precio habitual A partir de $1.75Precio habitualPrecio de oferta A partir de $1.75 -
Kit de recambio de caja de zapatos de 6qt | Combo De Champiñones Y Granos
Proveedor:Mycologysimplified4.68 / 5.0
(25) 25 reseñas totales
Precio habitual A partir de $15.99Precio habitual$19.99Precio de oferta A partir de $15.99Oferta
Featured collection
-
Sustrato de hongos no tan simple
Precio habitual A partir de $10.00Precio habitualPrecio de oferta A partir de $10.00 -
Pre Poured Sorghum Yeast Agar for Fungi Culturing – Sterile, High-Quality Sorghum Yeast Agar
Precio habitual A partir de $7.99Precio habitualPrecio de oferta A partir de $7.99 -
Engendro de grano de champiñones de maíz goteante
Precio habitual $10.00Precio habitualPrecio de oferta $10.00 -
Engendro de grano de champiñón estéril Milo / Sorgo de 3 lb
Precio habitual $17.99Precio habitualPrecio de oferta $17.99